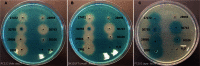

Cross-Talk between Staphylococcus aureus and Other Staphylococcal Species via the agr Quorum Sensing System
- PMID: 27877157
- PMCID: PMC5099252
- DOI: 10.3389/fmicb.2016.01733
Cross-Talk between Staphylococcus aureus and Other Staphylococcal Species via the agr Quorum Sensing System
Erratum in
-
Corrigendum: Cross-Talk between Staphylococcus aureus and Other Staphylococcal Species via the agr Quorum Sensing System.Front Microbiol. 2017 Jun 8;8:1075. doi: 10.3389/fmicb.2017.01075. eCollection 2017. Front Microbiol. 2017. PMID: 28607550 Free PMC article.
-
Corrigendum: Cross-Talk between Staphylococcus aureus and Other Staphylococcal Species via the agr Quorum Sensing System.Front Microbiol. 2017 Oct 5;8:1949. doi: 10.3389/fmicb.2017.01949. eCollection 2017. Front Microbiol. 2017. PMID: 29021792 Free PMC article.
Abstract
Staphylococci are associated with both humans and animals. While most are non-pathogenic colonizers, Staphylococcus aureus is an opportunistic pathogen capable of causing severe infections. S. aureus virulence is controlled by the agr quorum sensing system responding to secreted auto-inducing peptides (AIPs) sensed by AgrC, a two component histidine kinase. agr loci are found also in other staphylococcal species and for Staphylococcus epidermidis, the encoded AIP represses expression of agr regulated virulence genes in S. aureus. In this study we aimed to better understand the interaction between staphylococci and S. aureus, and show that this interaction may eventually lead to the identification of new anti-virulence candidates to target S. aureus infections. Here we show that culture supernatants of 37 out of 52 staphylococcal isolates representing 17 different species inhibit S. aureus agr. The dog pathogen, Staphylococcus schleiferi, expressed the most potent inhibitory activity and was active against all four agr classes found in S. aureus. By employing a S. aureus strain encoding a constitutively active AIP receptor we show that the activity is mediated via agr. Subsequent cloning and heterologous expression of the S. schleiferi AIP in S. aureus demonstrated that this molecule was likely responsible for the inhibitory activity, and further proof was provided when pure synthetic S. schleiferi AIP was able to completely abolish agr induction of an S. aureus reporter strain. To assess impact on S. aureus virulence, we co-inoculated S. aureus and S. schleiferi in vivo in the Galleria mellonella wax moth larva, and found that expression of key S. aureus virulence factors was abrogated. Our data show that the S. aureus agr locus is highly responsive to other staphylococcal species suggesting that agr is an inter-species communication system. Based on these results we speculate that interactions between S. aureus and other colonizing staphylococci will significantly influence the ability of S. aureus to cause infection, and we propose that other staphylococci are potential sources of compounds that can be applied as anti-virulence therapy for combating S. aureus infections.
Keywords: Staphylococcus aureus; Staphylococcus schleiferi; agr; anti-virulence therapy; auto-inducing peptide; cross-talk; quorum sensing; quorum sensing inhibition.
Figures

References
-
- Baldry M., Kitir B., Frokiaer H., Christensen S. B., Taverne N., Meijerink M., et al. (2016). The agr inhibitors solonamide B and analogues alter immune responses to Staphylococccus aureus but do not exhibit adverse effects on immune cell functions. PLoS ONE 11:e0145618 10.1371/journal.pone.0145618 - DOI - PMC - PubMed
LinkOut - more resources
Full Text Sources
Other Literature Sources
Miscellaneous

